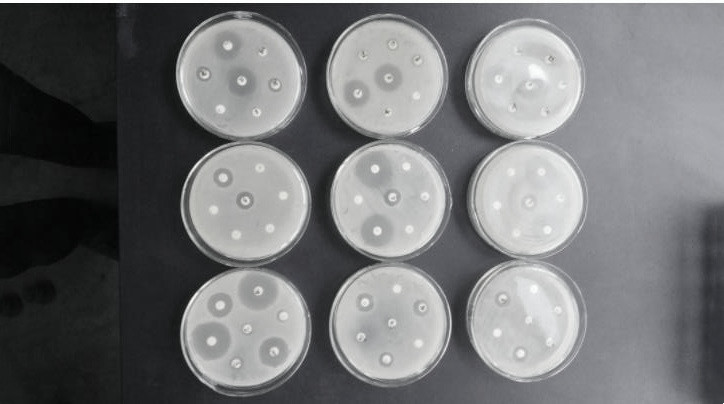
怎么快速检测蛋鸡滑液囊支原体,鸡的滑液囊支原体如何防控

据易邦生物技术保障中心监测与统计大数据显示:滑液囊支原体在蛋鸡养殖场内流行率很高,实际上,滑液囊支原体在鸡的流行病中也排到第三位(见下图),可见滑液囊支原体流行之广泛。

图1.2022年1-7月家禽疫病流行汇总分析
问题来了,鸡群预防和发生滑液囊支原体,我们都直接选用恩诺沙星,泰乐菌素、替米考星、金霉素、强力霉素、氟苯尼考就可以吗?
实际上到底选择哪种药物,当然拿来主义最快,但是,每个地区流行的毒株和用药习惯有差异性,还有预防和治疗用药也不同,同时,肉鸡和蛋鸡, 特别是产蛋鸡的用药有严格的规范与要求( 具体见关于印发《蛋鸡产蛋期安全用药管控技术性指导意见》,养蛋鸡的一定要仔细看 ),鸡群滑液囊支原体真发病了, 标准还是支原体分离鉴定,后续做药敏实验(但存在实验分离菌株周期相对长、操作繁琐)。
药敏实验
今天分享的 第一个药敏实验研究内容 是2018年宁夏某蛋鸡公司和大学合作做的关于宁夏地区滑液囊支原体分离鉴定与药敏实验结果:在宁夏发病地区采集87份疑似感染鸡的病料, 分离得到13株滑液囊支原体, 每个分离地随机挑选1 株进行抗菌药物的敏感性试验。
结果显示, 酒石酸泰万菌素 的敏感性最高; 泰乐菌素、泰妙菌素 敏感性次之;
磷酸替米考星、盐酸林可霉素大观霉素、多西环素 ,;土霉素和氟苯尼考的敏感性最差(具体表1)。
( 注解 : MIC 是minimum inhibitory concentration缩写,指最低抑菌浓度,最低抑菌浓度是测量抗菌药物的抗菌活性大小的一个指标,指在体外培养细菌18至24小时后能抑制培养基内病原菌生长的最低药物浓度。 翻译一下就是具有最低有效浓度分数的药物是更有效的抗菌剂 。)

表1. 9种常用抗生素对3株分离滑液囊支原体株最小抑菌浓度
泰万菌素>泰乐菌素>泰妙菌素>替米考星>恩诺沙星>多西环素>土霉素>氟苯尼考。
第二个药敏实验案例 是2019年河北某蛋鸡公司做的关于滑液囊支原体的药敏试验;样本来自滑液囊支原体某阳性种鸡场,经过检测选择300只阳性淘汰母鸡试验场单独饲养。
具体用药方案如下图:

表2. 各实验组药物使用方案
用药后的支原体监测方法与结果:
用药后每10天采一次腭裂棉拭子,到用药后30天为最后一次采样。即采腭裂棉拭子时间点为:开始用药后第10天,开始用药后第20天,开始用药后第30天。以上采集样品用荧光PCR(探针)检测滑液囊支原体病原。

表3.用药后滑液囊支原体qPCR阳性率

图2. 用药后用药组三次滑液囊支原体(MS) qPCR 平均阳性率
从上面的结果我们可以看出, 第一无论哪种药物或哪个药物组合,都不能完全杀灭支原体,只能说减少了鸡群中的支原体阳性率;
第二根据该图得到的结果,根据用药后滑液囊支原体 qPCR阳性率三次检测,试验五组沃尼妙林、六组金霉素、八组强力霉素、支原净一组用药方案效果良好;
三组替米考星,九组强力霉素、支原净、二组泰乐菌素效果差;
该种鸡场可以使用五组 沃尼妙林、六组金霉素、八组强力霉素、支原净一组试验组用药方案进行轮换用药。

从上面两个试验结果 我们可以看出,不同地区的支原体对同一种药物的敏感性不一样 ,比如泰乐菌素在第一个案例很敏感,在第二个案例不敏感效果很差( 除了当地流行的滑液囊支原体的不同是可能的原因,也可能是当地用药习惯,比如早期一直用泰乐菌素,用的时间久,现在滑液囊支原体对它有抗性;还有一种可能,不同公司生产的泰乐菌素品质有差异 )。
第三个药敏实验 是2015年南京一个公司和江苏农科院做的药敏试验,结果是泰乐菌素比较敏感,具体排序: 泰乐菌素>替米考星>林可霉素>氟苯尼考>盐酸土霉素>庆大霉素 ;金霉素、红霉素、卡那霉素敏感性显著下降;恩诺沙星、盐酸环丙沙星敏感性较差(详情见表4)。

表4.12种抗生素对滑液囊支原体株与分离株的药敏试验测定结果
看了这三个药敏实验结果,是不是有些困惑,到底用哪种药物较好?
药敏试验主要针对已经发病鸡群治疗的,越敏感越好;预防一般是用抗生素抑制支原体,可以用一些便宜,相对敏感性没有那么高的药物。
综合考虑效果和成本,如果是 预防净化,还是以金霉素、土霉素、泰乐菌素(大部分地区敏感性好,价格美丽)和强力霉素轮换用药为主。

鸡群已发生滑液囊支原体,与预防的方案不同,除了抑制和杀灭一部分滑液囊支原体,还要考虑滑液囊支原体在鸡群这个大的“培养罐”中额外消耗大量的氨基酸、维生素以及合成抗体需要的物质,此时也需要我们给鸡群补充营养和提高免疫力。
滑液囊支原体治疗方案是: 抗生素联合用药+提高免疫力(转移因子、黄芪多糖)+补充营养(氨基酸+多维等) ,比如方案: 强力霉素+泰乐菌素/泰妙菌素+转移因子(饮水或注射)+复合多维氨基酸 ,这样才能更快的控制滑液囊支原体( 提醒以上方案是针对肉鸡、蛋鸡育成期,用药要考虑严格休药期,需要专业兽医给开处方 ) 。
总之,建议养蛋鸡、种鸡以及长日龄的黄鸡:
一是做好平时生物安全(定期消毒、防止野鸟进入等);
二是全进全出、禁止多日龄混养(不同日龄鸡群易感性不一样);
三是最好定期检测滑液囊支原体抗原和监测滑液囊支原体抗体;
在鸡群没有发病的情况下,建议免疫安全性较好的灭活疫苗2次(3-4周龄,8-14周龄免疫灭活疫苗,0.3-0.5毫升/只皮下注射);
发生了滑液囊支原体有条件的做菌株分离并做药敏实验进行后续治疗。
这样就形成一个系统的防护方案,给鸡群更好保护。
以上是预防和可以用药的鸡群,如果是蛋鸡群发生滑液囊支原体,用抗生素弃蛋损失大,或者用药后效果不明显,依然大幅度降蛋该怎么办?
这些问题是养种鸡和蛋鸡经常碰到的,你还别说,编辑所在的团队在做流调过程中,还真发现了” 救命稻草 “;绝大多数鸡场用这个” 救命稻草 “的方案,恢复了滑液囊支原体造成的缓慢降蛋、破蛋和太阳蛋等问题,让产蛋率再次回到高峰;至于” 救命稻草 “是什么,限于文章篇幅,具体见下次讲解。
参考文献:
1.石晓磊, 齐田苗边海霞等. 宁夏地区鸡滑液囊支原体的分离鉴定与药敏试验.动物医学进展[J],2018,39(11):134-136
2. 王会峰 周守长 贺凯丽等. 鸡滑液囊支原体机体内药敏试验. 实验研究,2019年3月下
3. 丁美娟、卢凤英、严 鹏等. 鸡滑液囊支原体 不 同地 区分离株对常用抗菌药物的敏感性试验[J]. 中国兽药杂志,2015 ,49 ( 10 ) :5 2~55